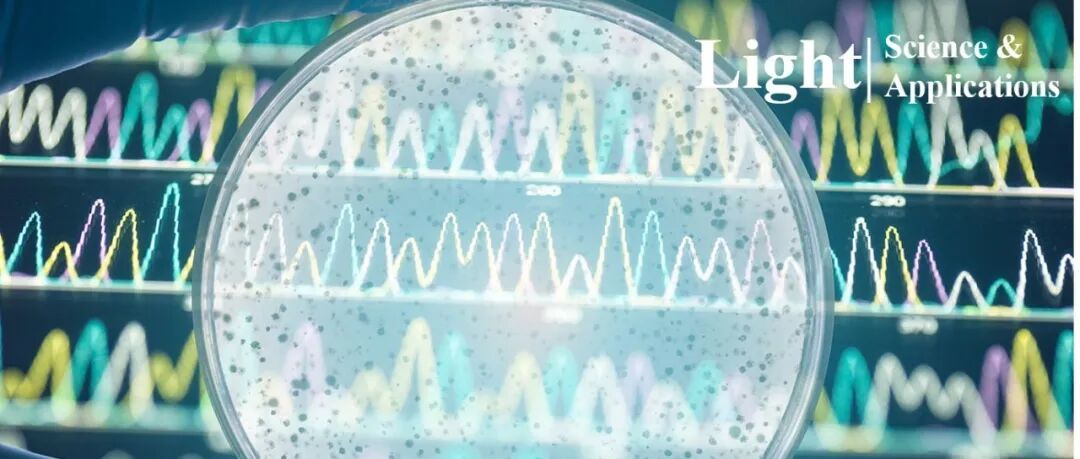

郭旭涵、苏翼凯团队Light | 微型混沌辅助光谱仪
LightScienceApplications
2025-10-14 11:30
文章摘要
背景:随着便携式应用的发展,传统光谱仪因体积庞大难以平衡小型化、高分辨率与大带宽的需求,微型计算光谱仪成为研究热点。研究目的:针对现有计算光谱仪需复杂结构增强随机性导致尺寸较大的问题,研究团队提出基于单个混沌微盘的微型光谱仪方案,旨在突破带宽、分辨率与尺寸的三重权衡。结论:通过边界形变激发光学混沌,在20×22μm²尺寸和16.5mW低功耗下实现了10pm高分辨率和100nm宽带宽,验证了双峰、三峰及连续光谱的高精度重建能力,且方案具跨材料移植性,为便携光谱传感提供新路径。
本站注明稿件来源为其他媒体的文/图等稿件均为转载稿,本站转载出于非商业性的教育和科研之目的,并不意味着赞同其观点或证实其内容的真实性。如转载稿涉及版权等问题,请作者速来电或来函联系。
推荐文献
Resonator-enhanced distributed Bragg reflector lasers.
DOI: 10.1038/s41377-026-02249-x
Pub Date : 2026-03-03
Polarization-Resolved Characterization of Antenna-Mediated Scattering in Transflection s-SNOM
DOI: 10.1021/acsphotonics.5c02630
Pub Date : 2026-03-11
Characterizing Muscle Components in Intestinal Strictures Using Spectroscopic Photoacoustic Imaging
DOI: 10.1002/jbio.70237
Pub Date : 2026-02-11
LightScienceApplications

王占山/张锦龙等LAM综述 | 强激光薄膜:突破高能激光系统瓶颈.
2025-12-30

Light | 等离子体钛酸钡-氮化硅平台:光通信中突破 200 GBd 高速调制.
2025-12-29

LAM综述 | AR头戴显示器的工业应用:设备性能与使用体验.
2025-12-28

2025-2026年度“Seed of Light”星光奖学金评选结果公布.
2025-12-27

eLight | 神经阵列超透镜实现轻薄彩色成像.
2025-12-26
最新文章

王占山/张锦龙等LAM综述 | 强激光薄膜:突破高能激光系统瓶颈
2025-12-30

Light | 等离子体钛酸钡-氮化硅平台:光通信中突破 200 GBd 高速调制
2025-12-29

LAM综述 | AR头戴显示器的工业应用:设备性能与使用体验
2025-12-28

2025-2026年度“Seed of Light”星光奖学金评选结果公布
2025-12-27




